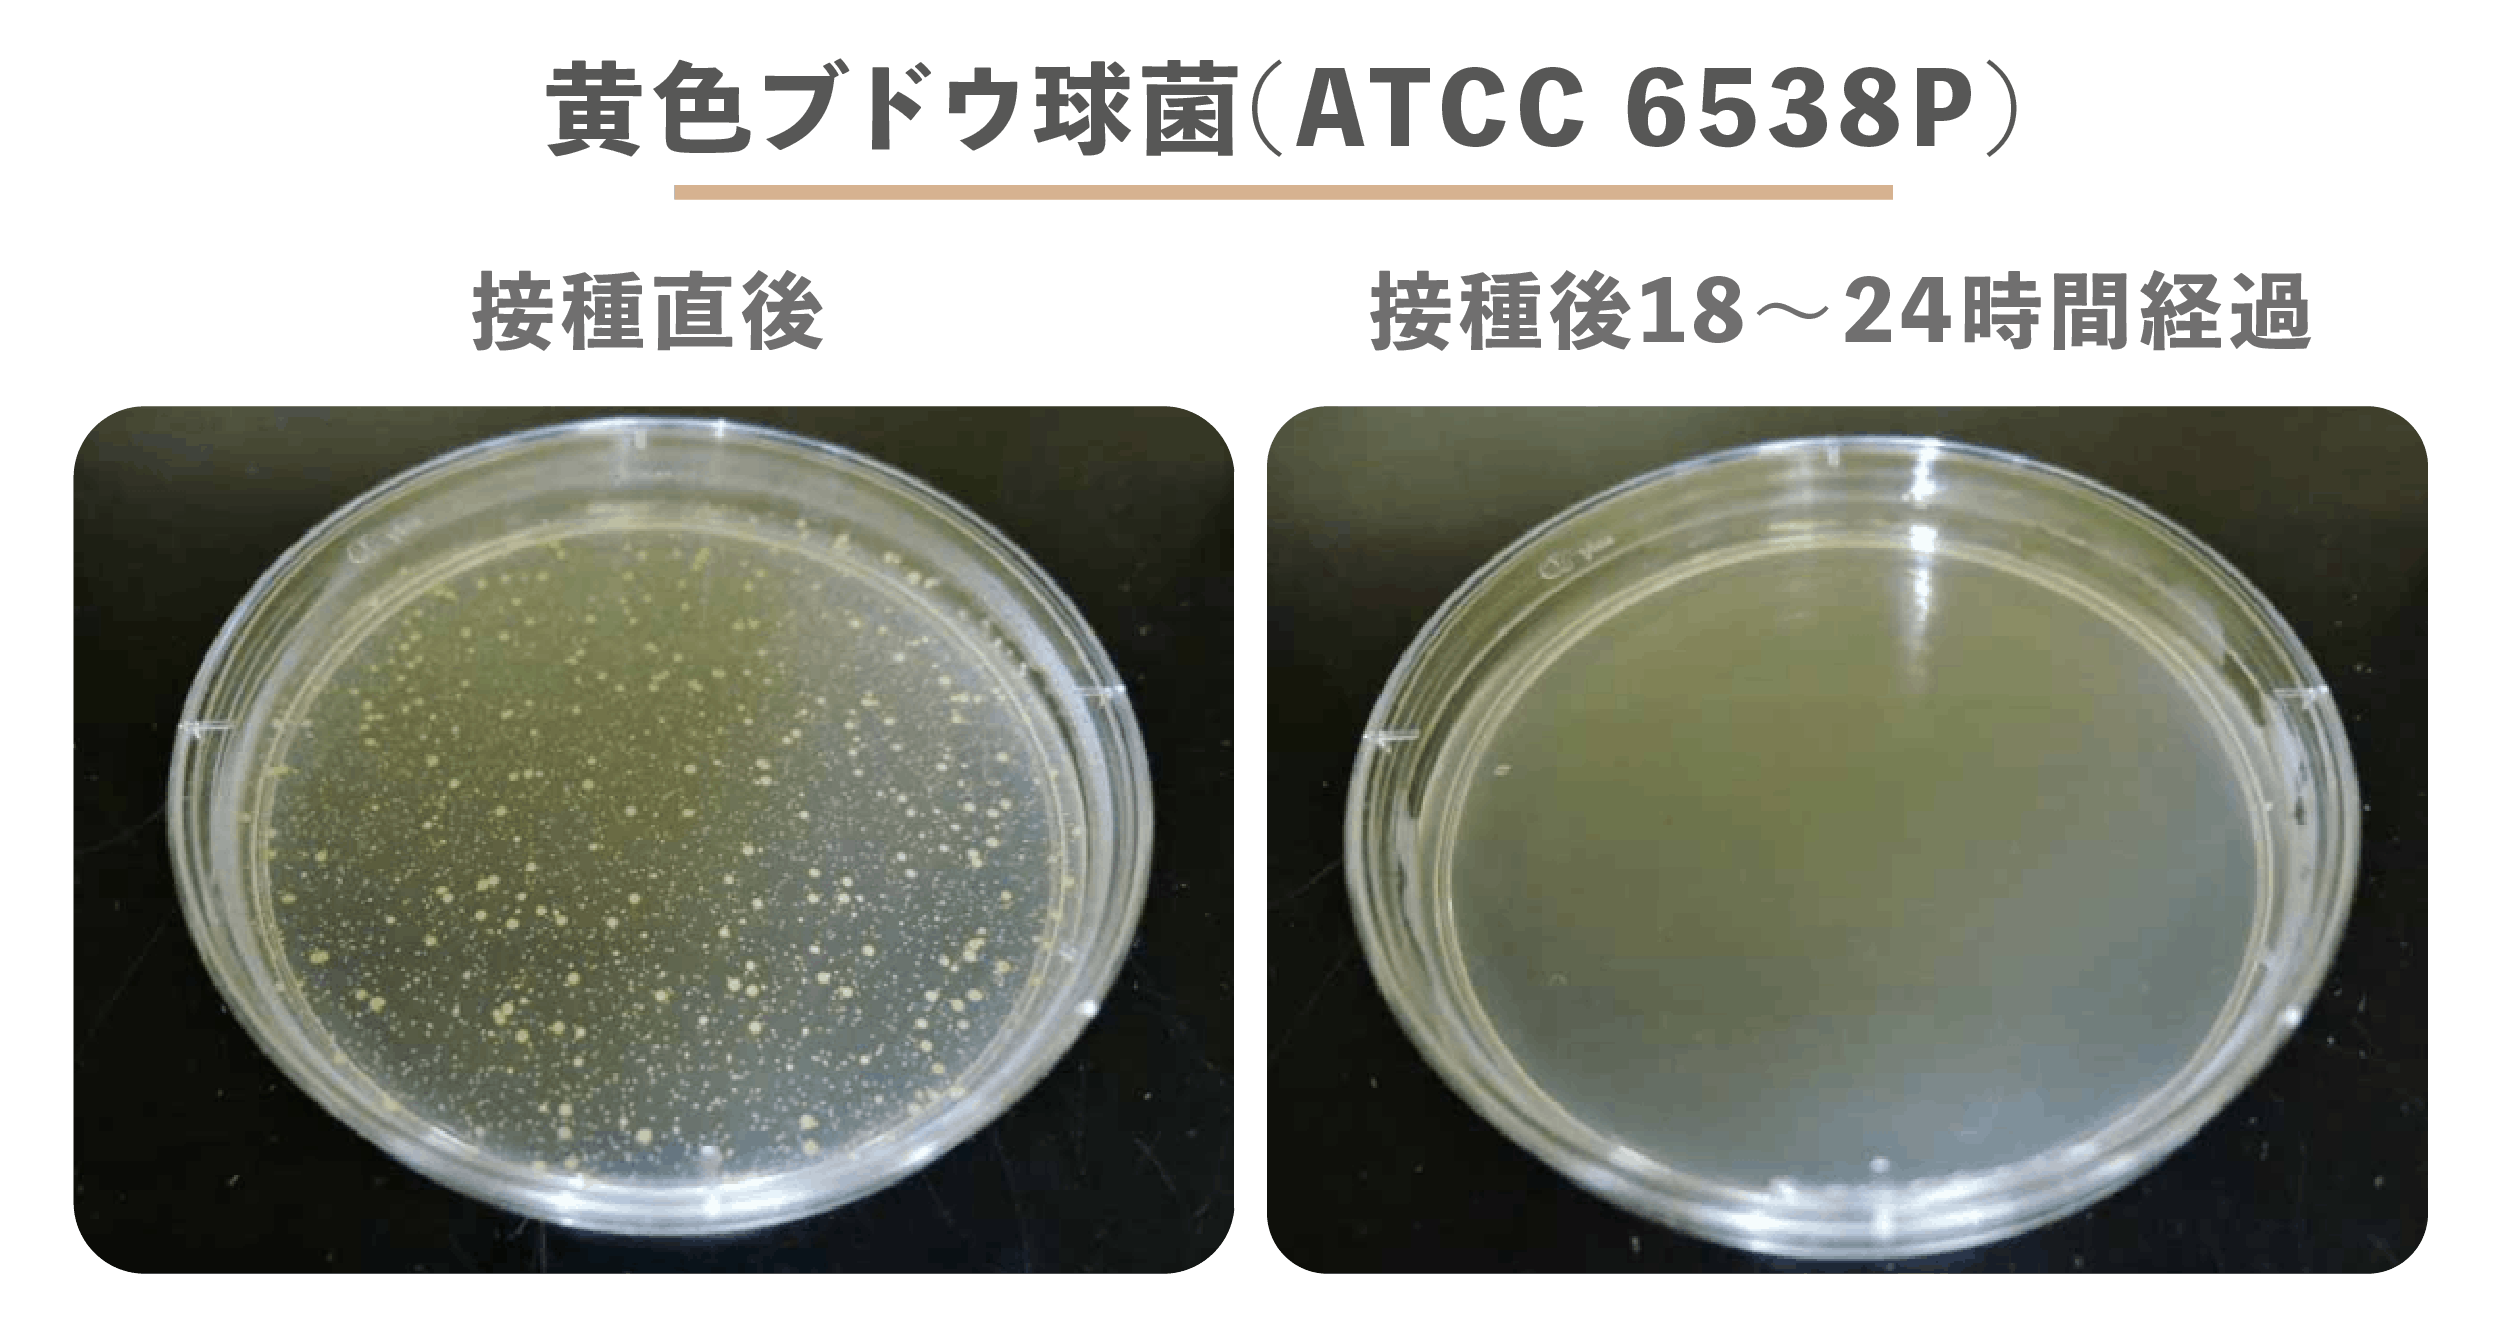

当社は有害な化学物質や重金属を使わず、世界中で愛されるスパイスを原料にTシャツを作り続けています。KOUP Tシャツはぴったりと身に付き、防臭効果が施され、速乾性で非常に軽量に作られています。フレッシュで快適な着心地がいつでも得られます!


特許取得済みの技術を活用してシナモン抽出液を紡績糸に浸透させており、効果は洗い落ちしません。



毎年、多くの人が大量に服を捨てています。ほとんどは埋め立て地に送られるか、ひどい場合は海洋投棄されることもあります。廃棄される服の多くはポリエステルやコットンなど複数の異なる素材が用いられているため、リサイクルが非常に困難です。しかし、KoupのシナモンTシャツならそんな心配は無用です!当社のTシャツはリサイクル素材をなるべく利用して製造されるだけでなく、使い終わったらリサイクルできるようになっています。


汗が臭うのは、バクテリアが汗に含まれるタンパク質を分解して、臭いを伴う酸へ変質させるためです。汗をかいても臭わないようにするには、こうしたバクテリアを皮膚から除去するか、成長させないようにする方法が有効です。当社はシナモン抽出液を加えた生地を使用して、皮膚で臭いを出すバクテリアで最も一般的な黄色ブドウ球菌の防止効果を検証しています。
左側の写真は、バクテリアがペトリ皿へ投入された直後の様子を示します。ご覧いただけるように、白い斑点はバクテリアです!シナモン生地と接触して18~24時間後、ほぼすべてのバクテリアが生地の表面から除去されています。シナモンTシャツでは臭いを発生するバクテリアが成長できないため、汗をかいたあとのやっかいな臭いが消え、いつでもフレッシュな感じを保てます。

さらに、当社はシナモン抽出液をリサイクル品のポリエステルへ浸透させた後、紡績糸、生地、衣服へ加工する特許取得済みの技術を用いています。化学物質や重金属を用いたコーティングは一時的な効果しかなく、5回程度洗っただけで落ちてしまうこともありますが、当社の防臭効果はTシャツの寿命期間、持続します! Tシャツを20回洗った後に抗菌特性を試しましたが、効果は全く衰えていませんでした。
通常、吸湿性は生地に化学物質をコーティングして得られます。KoupのシナモンTシャツは化学物質に頼らず、素材自身の特性を利用して吸湿性を実現します。毛細管現象を促進する独自の断面形状をもった、より高価なカスタマイズの紡績糸を使用しています。そのため、皮膚から素早く水分が押し出され、運動後も乾いた快適な状態を保ちます。
吸湿性を高めた特殊紡績糸の断面
KoupのシナモンTシャツはテクスチャ加工を施されたジャカード構造(生地に多くの気孔が存在します)を採用しており、生地を通じて空気や汗が自由に移動できます。このため、体温が生地を通じて外気へ放散され、心地よくTシャツを着ていられます。
ジャカード生地のクローズアップ

高度な編機で極細の紡績糸と微細なゲージを使用することで、生地の大幅な軽量化に成功しました。KOUP Tシャツは、通常のコットンTシャツよりも平均して30%軽くなっています。Tシャツの軽量性を証明するため、メンズとウィメンズのラージサイズで重量を測ってみました。メンズのラージサイズはわずか98g、ウィメンズのラージサイズにいたっては68gと、素晴らしい結果が得られています。対して、コットンTシャツはメンズのラージサイズで約130gとなるのが普通です。


当社の画期的なニット方式、Agile-fit™(アジャイルフィット)はどんな体型にも合わせられ、新たに改良された生地はそれまでよりも長く引き伸ばせます。アジャイルフィットを使用することで、生地の引っ張り距離が約30%伸びています。
新生地(左) vs. 旧生地(右)


KoupのシナモンTシャツは有害な化学物質を一切使用せず(REACH & OEKO-TEX準拠)、リサイクル素材(グローバルリサイクル基準で認定された紡績糸メーカー)を採用しています。ブルーサイン認証を受けた染料ミルを使用して生地を着色しており、衣料工場は世界規模の責任ある認定生産(WRAP)の認証を受けています。当社の製品を真に環境に配慮させるため、持続可能性に関して業界で最も厳しいテストを経たメーカーのみから素材を仕入れています。
取得している環境認証の一覧
さらに一歩先を進め、当社は廃棄された切地をパッケージに利用し、生物分解性の配送バッグを使用して、環境に対する影響を一段と抑えています。完全に環境保護のループを閉じるため、当社のTシャツは単一の素材のみを用いて製造されており、完璧なリサイクルを実現しています。













レギュラーフィットのTシャツは欧州サイズを基にデザインされています。ぴったり合うサイズがなくても、サイズを落として身体にしっかりと合わせたり、サイズを上げてリラックスした着心地を得られます。



シナモンTシャツはシナモンの匂いがしますか?
残念ですが、私たちもお気に入りのシナモンの香りは紡績工程で放散してしまうため、当社のTシャツはシナモンの匂いがしません。
シナモンTシャツはどう手入れすればいいのですか?
Tシャツは洗濯機にかけられ、また低温で乾燥機にもかけられます。しかし、当社は持続可能性と省エネルギーを目指しており、そのためTシャツも速乾性です。ぜひ、手洗いの後に陰干ししてください。Tシャツをさらに末永くお使いいただけます。
防臭効果はすべての臭いを消せますか?
当社の防臭技術は「臭いを発する」バクテリアの成長を防ぐ作用がありますが、料理やタバコなどの臭いがシャツに付着した場合は効きません。
Tシャツがリサイクル可能と言える理由は何ですか?
KOUP Tシャツはリサイクル品のポリエステルを使用しており、再利用が難しいスパンデックスやポリエステル綿などの混合素材は使用しておらず、リサイクルを基本としてデザインされています。
製造国はどこですか?
KOUP Tシャツはベトナムで製造されています。カーボンフットプリントを最小限に抑えるため、地元の工場を使用しています。
最新の活動報告
もっと見る発送完了のお知らせ
2020/11/22 22:44支援者の皆様お世話になっております。今週にすべての方へのTシャツを発送いたしました。来週中に届くとは思いますが、地域によっては遅れて来週に届く方可能性もありますのでご了承願います。再来週に届いていない方はご連絡頂ければ確認させて頂きます。改めて応援購入してくださった皆様、誠にありがとうございました!今後ともよろしくお願いします。KOUP もっと見る生産遅延のお知らせ
2020/10/19 18:39支援者の皆様いつもお世話になっております。ご支援いただきましたKOUPの納期遅延についてご案内をいたします。10月上旬のお届け予定と通知しておりましたが、生産の遅れにより、予定納期通りのお届けが難しい見込みとなりました。現在工場はフル稼働で商品の製作を進めており、11月中にお届けするよう、万全を期しております。到着を楽しみに待っていただいているところ大変心苦しいのですが、今しばらくのご猶予を賜りますよう、よろしくお願いいたします。最近毎日の気温差がコロコロ変わりやすくなっていますので、体調の変化に気を付けてくださいね。KOUP もっと見るリターン進捗状況につきまして
2020/09/08 17:48支援者の皆様この度はご支援いただき、ありがとうございました!皆様の注文内容をアンケートとメールにて確認させていただきました。ご協力、ありがとうございました!!本日工場へ正式発注して量産していただきます。引き続き品質の良い商品を早くお届けできるよう頑張ります!商品の配送に伴う進捗状況を随時ご報告させていただきます。何卒宜しくお願い致します!KOUP もっと見る







コメント
もっと見る